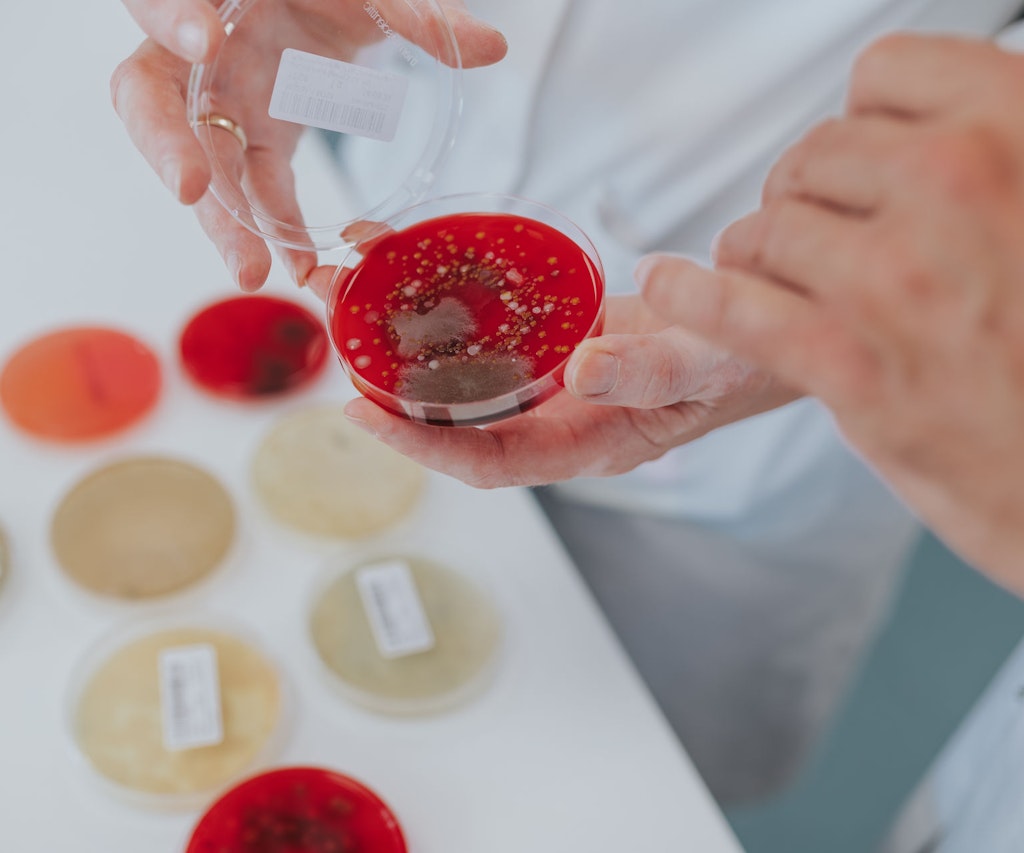
Pic6

In unserem Institut zählt jedes Detail - und jedes Teammitglied!
Im Institut Romeis vor den Toren des idyllischen Kurorts Bad Kissingen leistest du einen aktiven Beitrag zur Lebensmittelsicherheit. Jeden Tag erfährst du Unterstützung im Team, trägst Verantwortung und meisterst spannende Herausforderungen in der Lebensmittelanalytik.
Was dich bei uns erwartet:

Eigenverantwortliches
Arbeiten
Du übernimmst den kompletten Analyse-Prozess und erlebst dabei stets Abwechslung und spannende Aufgaben.

Lebenswertes
Umfeld
Unser Labor liegt in Mitten der Natur Nahe des Kurorts Bad Kissingen. Weg vom Stress der Großstadt.

30 Tage
Urlaub
Zeit für Erholung und Privates, ausreichend Freiraum für deine persönliche Balance.

Jobrad
für deine Gesundheit
Das fördert deine Fitness und tut gleichzeitig etwas für unsere Umwelt.

Finanzielle
Zusatzleistungen
Neben dem Gehalt gibt es bei uns Urlaubs- & Weihnachtsgeld sowie einen monatlichen Tankgutschein.

Individuelle
Wertschätzung
Uns ist es wichtig, dass jeder gesehen wird, deshalb unterstützen wir dich gerne in deiner persönlichen und fachlichen Entwicklung.

Gemeinsame
Team-Events
Wir arbeiten und feiern gemeinsam. Deshalb gibt es bei uns regelmäßige Teamfeste und unsere Weihnachtsfeier.

Echten Beitrag
leisten
Mit unserer Arbeit tragen wir Verantwortung für die Lebensmittelqualität in ganz Deutschland.

Herzliches Team
Mit rund 50 Mitarbeitenden pflegen wir eine familiäre Atmosphäre, in der sich jeder wertgeschätzt fühlt.
Unser Beitrag - Über Institut Romeis

Wo wir herkommen
Das 1975 von Peter Romeis gegründete Institut setzt seit jeher höchste Standards in der Lebensmittelanalyse und treibt Innovationen aktiv voran.
Seitdem haben wir uns von einem Labor zu einem führenden Institut entwickelt, mit einer eigenen Institutsbrauerei sowie einem Fokus auf Qualität und Weiterbildung. Die Überführung in die gemeinnützige Peter Romeis-Stiftung sichert unseren langfristigen Erfolg und bietet unseren Mitarbeitenden eine zukunftssichere und engagierte Arbeitsumgebung.
Wo wir heute sind und morgen hin wollen
Das Institut Romeis hat ein klares Ziel: Wir bieten nicht nur präzise Analysen von Mineralwasser, Bier und Kräutern, sondern auch umfassende Beratung sowie Schulungen, um höchste Qualitätsstandards zu sichern. Durch unsere Mitarbeit in diversen Gremien leisten wir einen Beitrag zu der Qualitätssicherung von Lebensmitteln.
Gemeinschaft und Freude an der Arbeit stehen für uns im Mittelpunkt. Wer bei uns arbeitet, wird Teil eines engagierten Teams, das zusammenhält, sich unterstützt und mit Leidenschaft innovative Lösungen entwickelt.
Soziales Engagement
regional & weltweit
Ob sauberes Trinkwasser, Zugang zu medizinischer Versorgung oder die Stärkung regionaler Gemeinschaften – die Peter Romeis-Stiftung engagiert sich Jahr für Jahr für zahlreiche soziale Projekte.
Dabei geht unser Einsatz weit über den Arbeitsalltag hinaus, denn echte Hilfsbereitschaft endet nicht bei uns selbst. Wir unterstützen Initiativen, die Menschen nachhaltig helfen und ihnen neue Perspektiven eröffnen. Mit jedem Projekt tragen wir dazu bei, Lebensbedingungen zu verbessern und Gemeinschaften zu stärken.
Denn für uns bedeutet Zusammenhalt mehr als nur Teamwork – es bedeutet Verantwortung für die Welt, in der wir leben.
Lerne uns kennen

Martina Denner
Bereich
Chemie
Unser Team im Bereich Chemielabor analysiert Wasser, Getränke und Bier umfassend und bietet Spezialanalytik für Verunreinigungen. Unsere Expertise im Lebensmittelrecht und Qualitätsnormen garantiert präzise Ergebnisse und fundierte Beratung. Verlasse dich auf uns für zuverlässige Analysen und maßgeschneiderte Lösungen.

Dr. Manuel Lange
Bereich
Mikrobiologie
Unser Team in der (Mikro-) Biologie bietet umfassende mikrobiologische Überwachung für Wasser, Getränke, Bier und Lebensmittel, einschließlich Schnellnachweisen und Identifizierung von Mikroorganismen. Mit moderner Technik und detaillierten Berichten unterstützen wir dich bei Qualitätssicherung und Hygiene-Monitoring.

Thomas Gehlert
Bereich
Beratung & Probenahme
Unser Team in der Probenahme & Beratung ist regelmäßig bei unseren Kunden in ganz Deutschland im Einsatz, übernimmt die Probenahme und bietet vor Ort umfassende Beratung. Dank des engen Kundenkontakts hat sich das Team vielerorts ein gutes Netzwerk aufgebaut, die die Basis für vertrauensvolle und langjährige Beziehungen bilden.
Das sagen deine zukünftigen Kollegen über die Arbeit bei Institut Romeis

Selina
Chemielabor
"Als Team halten hier immer zusammen und unterstützen uns wo es nur geht — hier gibt es kein gegen, sondern nur ein miteinander."

Uschi
Verwaltung
"Was ich hier besonders schätze, ist das Gefühl, wirklich Teil eines Ganzen zu sein. Jeder trägt seinen Teil bei, und gemeinsam schaffen wir Großartiges."

Marcus
Außendienst
"Unsere Arbeit ist so vielseitig und unsere Kunden total angenehm — die beste Branche, in der man arbeiten kann."

Angela
Mikrobiologie-Labor
„Ich arbeite seit 16 Jahren hier und liebe die abwechslungsreiche Produktpalette. Dazu kommt die familiäre Atmosphäre — hier fühlt man sich einfach wohl.“
Offene Stellen
Wir suchen engagierte Menschen, mit dem Auge fürs Detail und dem Fokus auf Qualität. Bei uns zählt Eigenverantwortung in einem unterstützenden Umfeld, wo jeder geschätzt wird.
Nicht das Passende dabei?
Kein Problem! Einfach initiativ bewerben und wir prüfen, ob deine Qualifikationen zu uns passen!
Bewerbung abgeschickt? Das sind die nächsten Schritte:

Noch Fragen?
Wir sind gerne für dich da
Dimo Brandt - Geschäftsführer
Tel.:
+49 (0) 9736 / 7516 - 22
E-Mail:
d.brandt[ät]institut-romeis [dot] de